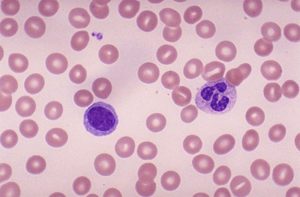
В мазке лейкоциты и эритроциты

Эритроциты в мазке на флору: норма, патология, лечение

В небольшом количестве эритроциты в мазке на флору говорят о нормальном состоянии женского организма.
Превышение нормальных показателей содержащихся эритроцитов во влагалищных выделениях считается признаком каких-то гормональных нарушений в женском организме и воспалительных процессов, которые могут внешне выражаться в виде неприятных, а в некоторых случаях и опасных заболеваниях.
В данной статье вы сможете ознакомиться с тем, зачем определяют эритроциты в мазке на флору, каковы нормальные показатели, а также о чем будут свидетельствовать отклонения от допустимых значений.
Зачем врачи берут мазок?
Мазки на флору представляют собой метод диагностики – изучение под микроскопом биоматериала, собранного с поверхностей слизистой оболочки влагалища у женщины.
Однако стоит обратить внимание на то, что анализ эритроцитов в мазке на флору делают всем: и женщинам, и мужчинам. Представителям сильнейшего пола мазок делают для выявления какого-либо урологического заболевания.
Материалы для исследования у мужчин берут непосредственно из уретры. У женщин же мазок может браться из уретры, а также влагалища.
Эти же анализы помогают обнаружить рак, фоновые и предраковые состояния. Мазок берется как с лечебной целью, так и с профилактической.
Во время прохождении курса терапии какого-либо заболеваний мочеполовой системы мазок обычно берется до начала лечения и после него.
Взятие мазка представляет собой совершенно безболезненную процедуру, помогающую верно оценивать состояние репродуктивной системы в организме женщины. Биоматериалы наносятся на предметное стекло, после чего изготавливается тонкий мазок, представляющий собой микропрепарат, пригодный для последующего изучения под микроскопом.
Материалы для исследований отбираются при помощи стеклянной пипетки или острой ложечки, а затем наносятся на край специального предметного стекла и размазываются ребром покровного. Мазки слегка подсушиваются на воздухе или на пламени горелки, после окрашиваются.
Существуют всего два метода окраски вагинальных мазков. Монохромный применяется в цитологическом анализе, что касается полихромного, то он используется для цитологического и гормонального исследования. После всех осуществленных манипуляций микропрепарат будет готовым для изучения под микроскопом.
Нарушение техники приготовления мазка может привести к недостоверному результату, но данная ситуация бывает крайне редко на практике, так как вагинальные мазки являются стандартным исследованием, которое от медработника не требует какой-то особенной повышенной квалификации.
Подготовка к забору биоматериала
Женщины должны приходить на забор мазка подготовленными.
Чтобы проведенный анализ оказался наиболее достоверным, необходимо воздерживаться на протяжении двух суток от полового контакта, не спринцеваться, не осуществлять терапию при помощи вагинальных свечей, кремов и мазей.
Рекомендуется также мочиться не раньше чем за три часа до похода в гинекологический кабинет. Желательно сдавать данный анализ на 5 сутки цикла, когда у женщины закончатся месячные.
Чтобы определить эритроциты в мазке на флору, перед сдачей материала мужчина тоже должен подготовиться: не заниматься за пару дней до посещения врача сексом, за несколько часов до сдачи анализа не курить и не употреблять алкогольные напитки.
Норма эритроцитов
Какое же количество этих тельцев должно присутствовать в биоматериале? В норме эритроциты в мазке на флору должны отсутствовать. Однако небольшое их количество нестрашно для организма и здоровья.
Какое количество эритроцитов в мазке на флору у женщин считается нормой, мы выяснили. Нормальным также считается имеющиеся в поле зрения доктора-лаборанта, который смотрит в окуляр микроскопа, нескольких телец. Увеличенное количество эритроцитов у женщин в мазке на флору говорит о протекании воспалительного процесса на шейке матки. Данный признак не прямой при этом, а косвенный.
Мазок у женщины с шейки матки должен браться специальной щеточкой с силиконовыми щетинами. При сильном воспалительном процессе шейки ткани становятся настолько ранимыми, что упругие щетины щетки расцарапывают до крови ее, а в мазок проникает огромное количество эритроцитов.
Что такое эритроциты?
В норме эритроциты в мазке на флору должны отсутствовать, или же их должно быть не более 3 в поле зрения. Но что это такое? Эритроцит представляет собой неэпителиальный элемент вагинального мазка.
Норма для эритроцитов в мазке на флору — располагаться не в слизи, а непосредственно в крови, где эти тельца переносят кислород из легких в ткань тела, а также транспортируют в обратном направлении углекислый газ. Эритроциты являются самыми многочисленными клетками в человеческом организме.
Статистика говорит о том, что каждая 4-я клетка в нашем организме — это эритроцит.
Такая форма и такой размер позволяют этим красным кровяным тельцам свободно двигаться по самому мелкому капилляру и иметь при этом достаточно обширную площадь поверхности, таким образом обеспечивая газообмен.
Попадание клеток в мазок
На слизистую шейки матки или влагалища попасть эритроциты могут лишь совместно с кровью. Эти тельца не покидают кровяное русло самостоятельно.
Чаще всего увеличение количества этих клеток происходит при заборе биоматериала для определения эритроцитов в мазке на флору.
Большое количество объясняется тем, что анализ берется мохнатой щеточкой, случайно которая может слегка поцарапать шейку матки.
Таким образом, в материал попадет некоторое количество крови. В данных случаях большое количество эритроцитов в мазке на флору — не патология, а абсолютная норма.
Кровь также может попасть непосредственно во влагалище не только по причине травмы. Повышены эритроциты в мазке на флору могут по естественным причинам, например, при менструации.
Эти тельца, обнаруженные в мазке в данное время — естественное явление, даже если они там находятся в большом количестве.
Единичные эритроциты в мазке могут появиться в определенные дни менструального цикла у женщины:
- во время овуляции (как правило, это 13–15-й день менструального цикла);
- на 28-й день (перед самым началом менструации).
Как было сказано ранее, эритроциты в мазке на флору отсутствуют в норме, но большое их количество в материале, взятом непосредственно с цервикального канала, указывает на развитие эрозии шейки матки или воспалительный процесс в этой области влагалища. Причина появления эритроцитов может заключаться во внутриматочных контрацептивах и гормональных нарушениях, сопровождающихся кровомазанием.
Эритроциты в биоматериале на цитологию
В некоторых случаях эритроциты в мазке у женщин можно обнаружить в биоматериале на цитологию. Происходит это по причине того, что специалист взял материал для мазка грубо и случайно при этом разрушил сосуды, которые проходят в нежной ткани шейки матки.
В данном случае после забора мазка несколько часов у женщины могут наблюдаться слабые выделения с небольшой примесью крови. Конечно, при данных обстоятельствах будет большое количество эритроцитов в мазке.
В этой ситуации присутствие кровяных телец не будет патологией.
Доктор, который взял материал для исследования, пометить в бланке, сопровождающем микропрепарат, настоящую причину имеющихся красных элементов – эритроцитов в мазке, в норме которые должны отсутствовать.
Эритроциты, которые были найдены в мазке из уретры, оказаться могут симптомами опухоли, камней, находящихся в мочевыводящих путях. В моче кровь никогда не будет нормой. Такое состояние говорит об остром воспалении, включая и воспаление бактериальной природы.
Самым распространенным обоснованием появления телец в мазке из уретры является травматический уретрит. Причиной такой патологии часто выступает проведение определенной медицинской процедуры, связанной с механическим попаданием крови в мочеиспускательный канал.
У мужчин
Мазок из уретры у мужчин на флору проводится специальным зондом, который вводится в канал на глубину примерно нескольких сантиметров. Процедура эта довольно болезненная, неприятная и может сопровождаться образованием на стенке уретры механической травмы.
У женщин
Мазок у женщин из уретры обычно берется в комплексе с биоматериалом с шейки матки, а также из влагалища. Данный анализ нужен, чтобы провести диагностику инфекционных болезней мочеполовых путей, дискомфорта в уретре и учащенного мочеиспускания.
Кроме того, мазки из уретры у представительниц прекрасного пола могут быть назначены как дополнительное обследование к посевам.
Чтобы взять такой мазок, доктор в уретру вводит на 2 – 4 сантиметра специальный аппликатор, а затем осторожно его вращает, чтобы собрать побольше эпителия.
Заболевание инфекционный уретрит вызывается разными патогенными микроорганизмами. Главный из его признаков будет появление выделений с кровью из мочеиспускательного канала. Объем данных выделений возрастает значительно по утрам.
Все перечисленные болезни будут обязательно сопровождаться образованием эритроцитов в мазке.
О мазке на флору
Нормальная микрофлора женского влагалища довольно разнообразна, она содержит в себе большое количество различных бактерий.
У представительниц слабой половины человечества репродуктивного возраста главными микроорганизмами являются лактобациллы, но кроме них также находят уреаплазм (у 80 % пациенток), гарднерелл (у 45 % пациенток), кандид (у 30 % пациенток) и микоплазм (у 15 % пациенток) — это условно-патогенные микроорганизмы, при снижении иммунной системы которые могут стремительно размножаться, а также приводить к возникновению воспалительного процесса. Они требуют назначения адекватного лечения. В отсутствии какого-либо клинического проявления, например, патологического выделения с неприятным ароматом или зудом в зоне промежности, определение данных микроорганизмов как патология трактоваться не должно.
Хламидии, а также вирусы могут находиться у пациенток, которые никаких жалоб не предъявляют, но данные агенты не считаются частью естественной микрофлоры, а их наличие указывает на скрытую инфекцию.
Микрофлора во влагалище динамична, она может меняться в разные дни цикла. Бывают такие периоды, когда лактобациллярная флора доминирует и те дни, в которые преобладает гарднерелла.
Значительно нарушение в микрофлоре баланса микроорганизмов, которое сопровождается клинической симптоматикой, находится в основе подобных состояний, например, бактериального вагиноза и кандидоза.
Такие состояния способны часто рецидивировать, включая даже малейшие изменения в состоянии здоровья пациентки или во время приема антибиотиков. Особенно от этого страдают женщины, у которых имеется семейная предрасположенность.
Мазок на флору (который также называется “общий мазок”) — это первый и немаловажный шаг при оценке инфекционно-воспалительного процесса, локализующегося в урогенитальной области. Такой мазок позволяет быстро выявить одно из нижеописанных состояний:
- Норма.
- Нарушения микрофлоры влагалища, куда следует отнести бактериальный вагиноз.
- Инфекция, которая вызвана грибами рода кандид, например, молочница.
- Инфекции, которые передаются половым путем, в частности, гонорея и трихомониаз.
- Неспецифический, или бактериальный, вульвовагинит. В таком случае в мазке лейкоциты присутствуют в большом количестве. При выявлении огромного количества лейкоцитов и наличии клиники воспалительного процесса возможно назначить антибиотики широкого спектра воздействия, которые уничтожают до 90% бактерий. В случае отсутствия лечебного эффекта необходимо осуществить бактериологический посев, так как микроскопически нельзя определить конкретный вид микроорганизма, который вызвал воспаление. Бакпосев сопровождается обычно выявлением чувствительности к антибиотикам, благодаря чему можно выбрать оптимальный препарат, а также достичь должного эффекта терапии.
Мазок на флору не способен определить:
- Внутриклеточные и скрытые инфекции (хламидии, микоплазмы, герпес, ВПЧ, уреаплазмы, ВИЧ). Для их определения обязательно определяется ДНК агента методом ПЦР.
- Беременность у женщины.
- Предопухолевую и опухолевую патологию. Делается мазок на цитологию, суть которого заключается в определении качественного изменения эпителия при помощи специальных окрасок.
Заключение
Теперь вы знаете о том, что содержание в мазке эритроцитов – не норма, а какое-то отклонение или симптом какого-либо заболевания. Причина появления красных клеток на поверхности слизистой влагалища может быть физиологической и патологической. В последнем случае пациентке надо пройти курс противовоспалительной терапии.
Эритроциты в мазке на флору у женщин: норма, причины повышения
В незначительном количестве эритроциты в мазке говорят о хорошем состоянии женского здоровья.
Превышение нормального показателя содержания эритроцитов во влагалищном отделяемом считается симптомом гормональных нарушений и воспалений, которые внешне могут выражаться в неприятных, а иногда и опасных заболеваниях.
Зачем берут мазок?
Мазок на флору — метод диагностики, представляющий собой изучение под микроскопом материала, собранного с поверхности слизистой. Анализ делают всем: и мужчинам, и женщинам.
Мужчинам делают мазок для выявления урологических заболеваний. Материал для исследования берут из уретры. У женщин мазок могут брать из уретры и влагалища.
Изучение микрофлоры и цитологического состава биоматериала, полученного путем соскоба или отпечатка слизистой, позволяет диагностировать инфекционные, в том числе венерические и гормональные заболевания, обнаружить рак, предраковые и фоновые состояния.
Мазок берут как с лечебной, так и с профилактической целью. При прохождении курса лечения заболеваний мочеполовой сферы мазок обычно берут до лечения и после.
Взятие мазка – совершенно безболезненная процедура, помогающая верно оценить состояние репродуктивной системы женщины.
Материал для исследования отбирают стеклянной пипеткой или острой ложечкой, а затем наносят на край предметного стекла и размазывают ребром покровного. Мазок слегка подсушивают на воздухе или в пламени горелки и окрашивают.
Существуют два способа окраски вагинального мазка. Монохромный используют в цитологическом анализе, полихромный применяют для цитологических и гормональных исследований.
После всех произведенных манипуляций микропрепарат считается готовым для исследования под микроскопом.
Нарушение технологии приготовления мазка приведет к недостоверным результатам, но такая ситуация бывает редко, так как вагинальный мазок — стандартное исследование, которое не требует от медработника особенной квалификации.
Женщина должна приходить на взятие мазка подготовленной. Чтобы анализ оказался достоверным, нужно воздерживаться двое суток от половых контактов, не спринцеваться, не лечиться с помощью вагинальных свечей мазей и кремов.
Рекомендуется мочиться не ранее чем за два или три часа до посещения гинекологического кресла. Желательно сдавать анализ на 5 день цикла, как только закончатся месячные.
Причины появления
Какое количество эритроцитов в вагинальном мазке считается нормальным? Норма, когда красных телец в мазке вообще нет.
Нормальным считается присутствие в поле зрения врача-лаборанта, смотрящего в окуляр микроскопа, двух-трех эритроцитов.
Увеличенное количество эритроцитов в мазке говорит о протекании на шейке матки воспалительного процесса. Этот признак не прямой, а косвенный.
Эритроциты — неэпителиальные элементы вагинального мазка. Норма для эритроцитов — находиться не в слизи, а в крови, где они занимаются переносом кислорода из легких в ткани тела и транспортируют углекислый газ в обратном направлении.
Эритроциты — самые многочисленные клетки в человеческом организме: каждая 4 клетка — эритроцит.
Каждую секунду в костном мозге формируются больше двух миллионов новых эритроцитов, которые выходят в кровь и приступают к выполнению своих важных функций.
Эритроциты человеческой крови – чрезвычайно мелкие клеточки, по форме похожие на диск, слегка вогнутый с обеих сторон.
Такие форма и размер позволяют красным кровяным клеткам свободно передвигаться по самым мелким капиллярам и при этом иметь достаточно большую площадь поверхности, чтобы обеспечивать газообмен.
Попасть на слизистую влагалища или шейки матки эритроциты могут только вместе с кровью — они не покидают самостоятельно кровяное русло.
В большинстве случаев увеличение количества эритроцитов происходит во время забора биоматериала, так как анализ берется мохнатый щеточкой, которая случайно может расцарапать шейку матки.
Кровь может попасть во влагалище не только вследствие травмы, но и по естественным причинам, во время менструации. Эритроциты, обнаруженные в мазке в это время — абсолютная норма, даже если они находятся в огромном количестве.
Единичные эритроциты могут появиться в вагинальном мазке в определенные дни цикла:
- в период овуляции (обычно это 13 – 15 сутки цикла);
- на 28 день (перед началом менструации).
Большое количество эритроцитов в материале, взятом с цервикального канала, говорит о развитии эрозии шейки или воспалительных процессов в этой части влагалища.
Причиной появления эритроцитов могут спать внутриматочные контрацептивы и гормональные нарушения, сопровождающиеся кровомазанием.
Эритроциты в других мазках (на цитологию, из уретры)
Иногда эритроциты можно обнаружить в мазке на цитологию. Это происходит из-за того, что доктор взял материал на мазок грубо и случайно разрушил сосуды, проходящие в нежных тканях шейки матки.
В таком случае после взятия мазка у женщины несколько часов могут наблюдаться несильные выделения с небольшим количеством крови.
В такой ситуации присутствие эритроцитов не является патологией. Доктор, взявший материал на анализ, отметит в сопровождающем микропрепарат бланке настоящую причину появления красных элементов крови.
Причины появления красных телец могут быть самыми разными, начиная от места забора биоматериала и заканчивая независящими от состояния здоровья женщины обстоятельствами.
Эритроциты, найденные в мазке из уретры, могут оказаться симптомами опухолей, камней в мочевыводящих путях.
Кровь в моче никогда не является нормой. Это состояние говорит об острых воспалениях, в том числе бактериальной природы.
Травматический уретрит — самое распространенное обоснование появления эритроцитов в мазке из уретры.
Мазок из уретры на флору у мужчин проводится особым зондом, который вводят в канал на глубину несколько сантиметров.
Процедура болезненна, неприятна и легко может сопровождаться появлением на стенках уретры механических травм.
Мазок из уретры у женщин обычно берут в комплексе с мазком с шейки матки и из влагалища. Этот анализ нужен для диагностики инфекционных заболеваний мочеполовых путей, учащенного мочеиспускания и дискомфорта в уретре.
Кроме того, мазок из уретры у женщин может быть назначен как дополнительное исследование к посевам.
Для взятия мазка доктор вводит в уретру на 2 – 4 сантиметра аппликатор и осторожно вращает его, чтобы собрать много эпителия.
Инфекционный уретрит — заболевание вызывается патогенными микроорганизмами. Одним из его симптомов будет появление из мочеиспускательного канала выделений с кровью. Объем выделений значительно возрастает по утрам.
Все перечисленные заболевания обязательно будут сопровождаться появлением эритроцитов в мазке.
Причины появления красных кровяных клеток на поверхности влагалища могут быть физиологическими и патологическими. В последнем случае женщине потребуется пройти курс противовоспалительного лечения.
Эритроциты в мазке на флору у женщин: норма, причины повышения – Диагностика

Исследование влагалищной флоры нужно для выявления и идентификации бактерий и определения степени их опасности. Такой способ наименее затратен и популярен при диагностировании воспалительных процессов и болезней, которыми можно заразиться при половых сношениях.
Плюс метода — взятие мазка на анализ совершенно безболезненно. При заборе мазка возможны незначительные субъективно неприятные ощущения. Мазок берется при осмотре гинекологом, затем образец влагалищного содержимого помещают на лабораторное стеклышко.
Позже, по прибытии в лабораторию образец окрашивается для различения и идентификации микробов.
Что показывает гинекологический мазок на флору из влагалища у женщин, о каких инфекциях может идти речь? Обсудим в нашей статье.
Основные показатели в гинекологическом анализе
Среда влагалища у женщин в норме не является стерильной.
Множество микроорганизмов представляют собой флору влагалища. Среди этих микроорганизмов постоянно ведется конкурентная борьба за место и пищу.
- Самые распространенные представители влагалищной флоры — лакто- и бифидобактерии.
- Во многом они сами определяют микроклимат своего обитания, выделяя в процессе своей жизнедеятельности спирты, пероксид, кислоты, в том числе молочную, в результате чего рН влагалищной среды имеет значение в мазке на флору, характеризующее кислую среду.
- Эти бактерии выделяют ферменты, которые не позволяют другим микробам размножаться.
Так что выявляет мазок на флору у женщин?
Лейкоциты и эритроциты
В отобранном мазке выясняют количество белых и красных кровяных телец. Норма у здоровой женщины – лейкоцитов – 10–15, а эритроцитов – около 2.
Если анализ взят сразу после месячных, то количество лейкоцитов может быть вплоть до 25. Если пациентка в положении, то допускается уровень лейкоцитов не более 30.
Множество белых кровяных телец свидетельствует об инфекционном заболевании, тогда нужно пересдать анализ.
Здесь нужно учитывать все состояния, дополнительно влияющие на уровень лейкоцитов, — беременность, менструация, простудные заболевания. Если все эти случаи исключены, то подозревают воспалительный процесс.
Фагоцитоз
Что значит фагоцитоз в мазке на флору? Фагоцитоз – это процесс захвата и уничтожения чужеродных клеток (например, болезнетворных бактерий) лейкоцитами. В мазке может быть обнаружен незавершенный фагоцитоз – наличие непереваренных микробных клеток внутри лейкоцитов. Это случается при инфицировании или если организм подвергается:
- стрессу;
- неблагоприятной экологии;
- нерациональному питанию.
Цитолиз
Цитолиз в анализе означает наличие во влагалище невоспалительного процесса, обусловленного чрезмерным размножением особого типа лактобацилл, которые выделяют водород. Их неконтролируемый рост приводит к ощелачиванию влагалищной среды и цитолизу (разрушению) клеток эпителия.
Эпителий
- О чем говорит большое количество эпителия в мазке на флору у женщин, что делать, если его много?
- Наличие плоского эпителия в мазке на флору у женщин — норма при условии определенного его вида и количества.
- Нормальным считается нахождение в отобранном образце от 5 до 10 клеток плоского эпителия.
- При сдаче мазка на флору у гинеколога отклонения от нормы:
- Снижение количества или отсутствие эпителиальных клеток, что показывает отмирание эпителия в связи с повышением уровня тестостерона и/или понижением уровня эстрогена.
- Значительное превышение содержания эпителиальных клеток в мазке может появиться по следующим причинам:
- воспаление в слизистом слое стенок влагалища;
- болезни, которыми можно заразиться при коитусе;
- вагинит;
- кандидоз;
- воспаления шейки матки и мочеиспускательного канала;
- почечные и мочеполовые инфекционные и другие заболевания.
Заболеванием эктопия не является, но требует наблюдения.
Фибрин
Фибрин — это белок плазмы крови. Его обнаружение в мазке означает наличие воспалительного процесса.
Слизь
Слизь может быть у здоровых пациенток исключительно в мазке из влагалища. Если слизь обнаруживается, например, в уретре, то это говорит о воспалении. В образце из влагалища слизи может быть в норме умеренное или малое количество, что обозначается соответственно ++ и +.
Палочки Додерлейна
- Палочки Додерлейна должны в норме преобладать в микрофлоре влагалища.
- Это лактобациллы, выделяющие молочную кислоту, необходимую для образования нормальной влагалищной микрофлоры.
- Если лактобактерии присутствуют во влагалище в достаточном количестве, там не развиваются инфекции, поскольку молочная кислота не дает размножаться другим бактериям.
Если же количество этих полезных микроорганизмов снижено, то рН влагалища сдвигается в щелочную сторону. Может возникнуть воспаление.
В нормальном мазке лактобактерии составляют 95 % от всей флоры.
Условно-патогенная флора
В гинекологии условно-патогенными называют те микробы в мазке на флору, которые могут не вызывать никаких заболеваний, пока не начинают размножаться сверх меры. Основные разновидности таких микробов:
- кокки;
- уреаплазма;
- дифтероиды;
- грибы кандида.
Кокки
- Кокки – это бактерии округлой формы.
- По методу окрашивания бывают грамположительные и грамотрицательные.
- Грамположительные кокки (стафилококки, стрептококки и энтерококки) относятся к условно-патогенным, их наличие считается нормальным в пределах:
- стафилококков – до 104;
- стрептококков – до 105;
- энтерококков – до 105.
Грамотрицательные кокки – возбудители опасных заболеваний. К ним относятся гонококки – возбудители гонореи.
Уреаплазма
Это очень мелкие бактерии, которые при размножении свыше 104 единиц вызывают воспалительные заболевания. Они препятствуют зачатию.
Лептотрикс
Это представитель анаэробной УП флоры, грамположительный палочковидный микроорганизм. Сам по себе лептотрикс в мазке на флору опасен только во время беременности, способен спровоцировать выкидыш. У небеременных пациенток обнаружение лептотрикса – не повод для беспокойства.
Дифтероиды
Как представители УП флоры, они могут быть в мазке в небольших количествах. При превышении их уровня начинается вагиноз. Дифтероиды похожи на бактерии, вызывающие дифтерию, – коринебактерии.
Если в мазке на флору были найдены коринобактерии, определяют их количество. При умеренном количестве назначают курс лечения лекарственными препаратами. Если коринебактерий больше определенного порога, то нужно провести дополнительные исследования на наличие других инфекций, так как эти бактерии часто бывают ассоциированы с другими.
Клебсиелла
Представитель УП флоры, клебсиелла при определенных условиях (при снижении иммунитета, беременности) может вызывать болезни мочевыводящих путей.
Грибы Кандида (soor)
Что дает положительный soor в мазке на флору? Если из мазка выделены гриба рода Candida, это говорит о кандидозе.
Эти грибы – тоже представители УП флоры, они заносятся во влагалище извне. Кандидоз провоцируется снижением иммунитета. При кандидозе в мазке на флору могут быть найдены:
- нити псевдомицелия (мицелий).
Псевдомицелий представлен нитевидными разрастаниями из бластоспор с перетяжками:
Если в анализе влагалищного мазка на флору обнаружены бластоспоры, значит, организм этой женщины поражен кандидозом. Количество бластоспор зависит от распространенности и стадии болезни. Бластоспоры — зародышевые формы клеток, образовавшиеся путем почкования от материнских форм клеток.
Если в мазке на флору найдены бластоспоры, нужно провести обследование женского организма на дрожжевые споры грибов.
Ключевые (атипичные) клетки
Ключевые клетки в мазке на флору – это клетки эпителия, на поверхности которого собрались микроорганизмы (особенно это характерно для гарднерелл у женщин, вызывающих бактериальный вагиноз). Наличие в мазке атипичных клеток – признак инфекционного заболевания.
Скудность и обильность
По образцу мазка на флору выясняют тип микрофлоры:
- скудная – содержит только лактобациллы;
- средняя – лактобациллы +до 10 лейкоцитов;
- смешанная – лактобациллы +до 30 лейкоцитов + кокки;
- обильная – почти нет лактобактерий, очень много лейкоцитов, слизи и кокков.
Что определяет степень чистоты
По результатам анализа образца мазка на флору выделяют степени чистоты влагалища:
- Флора в основном представлена лактобактериями. Немного лейкоцитов, умеренное количество эпителиальных клеток, умеренное количество слизи. Норма, хороший местный иммунитет.
- Флора представлена лактобактериями + кокки + дрожжи. Немного лейкоцитов, умеренное количество эпителиальных клеток, умеренное количество слизи. Вариант нормы.
- Повышено количество лейкоцитов. Флора – кокки, дрожжи, грибы, лактобактерий мало. Много эпителиальных клеток и слизи. Воспалительный процесс, требует лечения.
- Лейкоциты повсюду. Флора – кокки, дрожжи, грибы, лактобактерий нет. Много эпителиальных клеток и слизи. Выраженный воспалительный процесс, требует лечения.
При 1 и 2 степени чистоты среда во влагалище кислая и слабокислая, в случае 3 и 4 – слабощелочная и щелочная соответственно.
Мазок у женщин на флору: норма (таблица), расшифровка, что значит
Несмотря на то, что лейкоциты в организме выполняют защитную функцию (их наличие в норме и активность определяют способность организма к сопротивляемости попавшим бактериям), обнаружение их большого количества в гинекологическом мазке на флору может свидетельствовать о наличии проблем.
Каждое посещение гинеколога в женской консультации должно предполагать обязательный забор материала из урогенитального тракта для проведения анализа (мазок на флору). Мазок у женщин берут при периодических осмотрах для профилактики, в период планирования и течения беременности, а также после родов, для контроля состояния женского организма.
Гинекологический мазок на флору необходим для определения количества лейкоцитов в мазке, а также наличия полезных и патогенных бактерий.
Повышенные лейкоциты в мазке на флору свидетельствуют о наличии воспалительного или инфекционного процесса, протекающего в организме.
Подготовка к сдаче мазка
Для максимальной достоверности результатов мазка на флору женщине необходимо подготовиться.
- за 2 суток исключить половые контакты
- за 2 суток не делать спринцевание
- за 1 сутки исключить использование вагинальных свечей и кремов, а также прием таблеток
- за 2 часа до сдачи анализа исключить мочеиспускание
- подмываться можно только накануне вечером до анализа, теплой водой без мыла
- запрещается сдача мазка во время месячных
В мазке лейкоциты и эритроциты – все про почки

Многие годы пытаетесь вылечить ПОЧКИ?
Глава Института нефрологии: «Вы будете поражены, насколько просто можно вылечить почки просто принимая каждый день…
Урина является одним из самых важных компонентов экскрементов человека. По составу мочи можно определить большое количество заболеваний и патологических процессов, протекающих в организме. В том числе и патологию со стороны самой мочевыделительной системы.
С мочой из организма человека выводятся самые основные продукты жизнедеятельности тканей и органов – их метаболиты, которые зачастую бывают токсическими при увеличении их концентрации в крови, одним из самых частых проявлений заболеваний мочевыделительной системы, когда лейкоциты и эритроциты в моче повышены. Это может свидетельствовать о различных воспалительных заболеваниях почек и мочевыделительной системы в целом.
Нормальный состав мочи
В норме урина состоит на 97% из воды, а остальные 3% приходятся на органические и неорганические продукты обмена веществ, которые формируют гомеостаз всего организма.
НАШИ ЧИТАТЕЛИ РЕКОМЕНДУЮТ!
С мочой происходит выделение мочевины, мочевой кислоты, креатинина, ионов натрия, хлора, кальция и магния. Также в моче определяются клетки эпителия почечных канальцев и мочевого пузыря, небольшое количество эритроцитов и лейкоцитов.
- Норма лейкоцитов – 3-5 в поле зрения;
- Норма эритроцитов в моче – 2-3 в поле зрения.
В норме в моче не должны быть обнаружены слизь и бактерии. Кроме определения показателей химического и клеточного состава мочи, важна оценка её плотности и цвета. В норме цвет урины может варьироваться от соломенно-жёлтого до ярко-жёлтого, а физиологичная относительная плотность составляет 1,010-1,025.
Причины увеличения эритроцитов в моче
Эритроциты – одни из самых важных кровяных клеток, которые отвечают за перенос кислорода, необходимого абсолютно всем тканям организма человека. Потеря большого количества красных кровяных клеток приводит к развитию анемии и нарушению функций большинства органов и систем организма.
В случаях с заболеваниями почек в моче наблюдается большое количество эритроцитов, что можно заметить невооружённым глазом. Состояние, при котором количество эритроцитов в моче повышается, в среде специалистов называется гематурией.
При визуальном осмотре мочи можно заметить, что она становится бледно-розовой окраски. При проведении специальных проб, таких как проба по Нечипоренко, можно провести анализ количества эритроцитов и лейкоцитов в урине.
Для дифференциальной диагностики и уточнения причины, вызвавшей гематурию, проводят микроскопию осадка мочи.
Характер эритроцитов при микроскопии
При проведении микроскопии можно не только выявить их количество в урине, но и определить форму, целостность эритроцитов.
Если в мазке наблюдаются выщелоченные (разрушенные) эритроциты, это говорит о наличии патологии со стороны гломерулярного аппарата почек.
Если же эритроциты неизменённой формы, их называют свежими. Такие эритроциты говорят о нарушении целостности по ходу урогенитального тракта или о цистите. Свежие эритроциты появляются в результате нарушения целостности сосудистой стенки и эпителиальной выстилки мочеточников, мочевого пузыря или уретры.
Причины повышения лейкоцитов в моче
Лейкоциты – это не менее важные клетки, чем эритроциты. Они отвечают за общий иммунитет организма. При появлении воспаления лейкоциты моментально инфильтруют место воспаления и помогают в борьбе с инфекционным агентом.
Причины появления клеток крови в урине весьма разнообразны и требуют дифференциально диагностического поиска для установления клинического диагноза. Высокий уровень лейкоцитов в урине называется лейкоцитурией и вызывается рядом инфекционно-воспалительных заболеваний мочевыделительной системы. Чаще всего содержание лейкоцитов в урине повышено у женщин.
Это происходит из-за анатомо-физиологических особенностей уретрального канала. При несоблюдении гигиенических норм инфекция (бактерии) может легко подниматься в мочевой пузырь по уретральному каналу. Легко за счёт того, что женская уретра более короткая и широкая, в отличие от мужской.
Зачастую лейкоцитурия сочетается с гематурией, особенно в случаях с воспалением мочевого пузыря, которое называется циститом.
Цистит – самая частая причина, при которой в урине обнаруживается слизь, бактерии, повышенное количество лейкоцитов и эритроцитов.
В случае если в урине лейкоцитов слишком много, можно говорить о воспалении почек – пиелонефрите или гломерулонефрите. При гломерулонефрите также значительно повышается белок в урине, концентрация которого прямо пропорциональна тяжести заболевания.
Также происходит увеличение экскреции ионов кальция и магния.
Наличие в мочевыделительной системе серьёзной и агрессивной инфекции, такой как гломерулонефрит или пиелонефрит, является серьёзной патологией и требует незамедлительного медикаментозного лечения.
Что нужно делать при повышении эритроцитов и лейкоцитов
Общий анализ мочи (ОАМ) является дешёвым и высокоинформативным методом определения состава урины, а также может показать количество лейкоцитов и эритроцитов.
При проведении специальных урологических анализов, таких как проба по Нечипоренко, можно узнать точное количество потери кровяных клеток с уриной. Интерпретация данных анализов позволяет определить тяжесть заболевания, а также во многом формирует тактику лечения заболевания.
Однако принципы лечения для большинства инфекционных заболеваний почек и мочевыделительной системы имеют общий подход.
В течение курса лечения и по его завершении обязательно проводят контрольные исследования с определением уровня лейкоцитов и эритроцитов в урине, чтобы отследить динамику выздоровления.
Какая норма лейкоцитов в моче?
Лейкоцитами называются бесцветные клетки, что выполняют защитную функцию организма. Второе наименование этих элементов – это белые кровяные тельца. При борьбе с различными болезнетворными факторами большое количество бесцветных клеток повреждается и экскретируются с уриной. Нормальное содержание белых кровяных телец различно для пола человека и возрастной группы.
Повышенные лейкоциты в моче свидетельствуют о наличии проблем со здоровьем. Игнорировать не стоит, поскольку отклонения от нормы нередко сигнализирует о развитии онкозаболеваний. Вот почему так важно знать, какой уровень лейкоцитов в моче является допустимым, и причины, способствующие росту концентрации бесцветных клеток.
Норма концентрации лейкоцитов
Присутствие небольшого количества лейкоцитов в моче считается нормой, которая зависит от половой принадлежности и возрастной категории пациента. Показатели количества белых клеток разнятся для лиц мужского и женского пола.
В моче женщины содержится большее количество лейкоцитов. Объясняется это анатомическим строением мочеполовой системы. Женская уретра короче и шире, чем мужская, гениталии расположены рядом, и бактерии свободно перемещаются, искажая параметры анализов мочи. Сколько же должно быть белых телец у здорового человека?
Нормальными показателями лейкоцитов, содержащихся в урине, считаются следующие цифры:
- норма лейкоцитов в моче у женщин составляет 0–5 клеток в поле зрения;
- норма лейкоцитов в моче у мужчин варьируется от 0 до 3 клеток в поле зрения.
Дополнительно проводится анализ Нечипоренко, для которого нормой является результат, не превышающий 4 тысячи клеток в 1 миллилитре. Проба Каковского-Адисса подразумевает результат, что не превышает 2 миллионов единиц в дневной дозе урины. Эти показатели считаются нормой для здорового человека, они помогают установить наличие либо отсутствие различных заболеваний.
У детей норма концентрации бесцветных клеток в моче несколько иная, чем у взрослых:
- для новорожденных девочек показатель концентрации лейкоцитов в урине составляет 8 клеток в поле зрения;
- для мальчиков грудного возраста допускаются показатели до 5 клеток.
В период прорезывания зубов у ребенка наблюдается безбактериальное воспаление зубной лунки, поэтому в детском возрасте отмечается повышение количества лейкоцитов в моче.
Анализ могут признать сомнительным в случае присутствия в жидкости 3–10 белых клеток. В подобной ситуации необходимо провести повторное исследование. Если повышенный уровень лейкоцитов в моче наблюдается и во второй раз, то это означает, что пациент болен. Для выяснения причины увеличенного количества белых телец производятся такие манипуляции:
- УЗИ почек;
- исследование мочи на предмет бактерий;
- соскоб эпителия.
Нарушение мер гигиены во время сбора материала также способствует искажению результатов.
Причины повышенного уровня
Большое количество лейкоцитов в урине называют лейкоцитурией. Ее не определяют как самостоятельную болезнь, а считают симптомом других аномалий. Если в анализе имеется пометка «лейкоциты сплошь» или число клеток превышает отметку 500, то пациенту следует срочно обратиться за врачебной помощью для проведения дополнительных диагностических мероприятий.
Для многих больных обоих полов является актуальным вопрос: почему повышены лейкоциты в моче?
Причиной этого явления могут послужить следующие причины:
- Цистит острого и хронического течения. Острая форма заболевания проявляется интенсивными болями, локализующимися в нижней части живота. Отмечается болезненность мочеиспускания, сильные и частые позывы. В отдельных случаях появляется выделение крови с уриной. Хроническая форма может протекать бессимптомно.
- Пиелонефрит и пиелит имеют сходную симптоматику. При остром воспалении почек повышаются температурные показатели до 38–39°C, возникает боль в поясничной области.
- Мочекаменная болезнь, новообразования. При этих заболеваниях лейкоциты в моче повышены, причиной этому служит попадание крови в урину, когда камень травмирует мочевыводящие пути. А также много белых телец наблюдается при наличии опухолей в почках, простате, мочевыводящих путях.
- Уретрит острого и хронического течения. Для острой формы патологии характерно возникновение болевых ощущений, учащением мочеиспускания и помутнением жидкости.
- Гломерулонефрит – воспаление почечных клубочков. При их поражении нарушаются процессы фильтрации, и через поврежденные стенки сосудов в мочу может проникнуть кровь. У больного повышается температура, возникает тошнота, сопровождающаяся рвотой, отеки на лице. Моча приобретает темно-коричневый или бурый цвет.
А также высокие показатели лейкоцитов в урине наблюдаются из-за сдерживания позывов к испусканию мочи. Нарушается деятельность мочевого пузыря, он теряет способность полностью опорожняться. В остаточной урине развивается инфекция и повышается уровень белых клеток.
Повышенное количество лейкоцитов в моче у женщин
В женском организме лейкоциты повышаются из-за проблем, связанных не с почками или организмом в целом, а именно – с патологиями гениталий женщины.
Однако у некоторых полностью здоровых женщин, ведущих активную половую жизнь, допустим умеренный рост белых телец в гинекологическом мазке – до 20–25 единиц.
К причинам, способствующим повышению концентрации защитных клеток в моче женщины, относятся перечисленные ниже заболевания:
- Бартолинит представляет собой воспаление железы преддверия влагалища. Для болезни характерен острый инфекционный процесс, в области гениталий возникает отек и боль.
- Аднексит является воспалительным заболеванием маточных придатков, которое может иметь острое или хроническое течение. Характеризуется появлением болевых ощущений с одной стороны живота, гнойных и обильных выделений из влагалища.
- Вульвовагинит – патология, характеризующаяся воспалением наружных половых органов и влагалища. Отмечается ощущение дискомфорта в области вульвы и влагалища, иногда заболевание сопровождается зудом. Характер выделений и цвет зависит от возбудителя.
Повышенные лейкоциты в моче во время беременности на начальном этапе являются нормальным явлением.
Оно обусловлено активностью защитных иммунных функций, стремящихся снизить антигенную нагрузку на организм. Небольшое увеличение концентрации бесцветных телец наблюдается при закреплении зиготы к стенке матки.
Норма лейкоцитов в моче у женщин в период беременности может колебаться от 9 до 10 единиц. Если наблюдается повышенное содержание лейкоцитов в моче продолжительное время, то это может сигнализировать о развитии патологии.
Повышенная концентрация лейкоцитов в моче у мужчин
Помимо перечисленных ранее факторов, характерных для обоих полов, дополнительно мужчинам необходимо знать, какие патологии мужских гениталий способствуют росту лейкоцитов. Причинами могут стать:
- Простатит, характеризующийся болезненным мочеиспусканием, затруднение оттока мочи, повышением температуры.
- Баланопостит, что является воспалением кожного покрова полового члена. К его симптомам относится зуд, жжение, болезненность в характерной области.
- Аденома простаты может долго протекать бессимптомно, до тех пор, пока патологически увеличенная железа не перекроет путь оттока урины. Проявляется прерывистостью мочевой струи, ее ослаблением. Мочеиспускание сопровождается болью.
- Рак простаты имеет сходную с аденомой симптоматику.
Большинство больных, у которых в анализах повышенная концентрация лейкоцитов, желают знать, что это значит. Не всегда увеличенное количество бесцветных клеток в урине указывает на заболевание.
Но правильный диагноз может поставить только специалист, поэтому при любых отклонениях от нормы, необходимо сразу же обратиться за врачебной помощью.